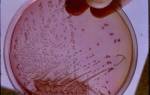

Климакс — естественный процесс в жизни каждой женщины, проявления которого зависят от возраста, в котором произошли роды. В статье рассмотрим симптомы климакса после ранних и поздних родов, а также методы лечения и профилактики. Понимание этих аспектов поможет женщинам подготовиться к изменениям в организме, снизить дискомфорт и сохранить качество жизни в этот период.
Климакс после ранних родов
Менопауза обычно наступает в возрасте от 45 до 55 лет, когда репродуктивная функция женщины начинает угасать. Однако, если менструация прекращается в 35 или 40 лет, это может вызвать беспокойство о серьезных проблемах со здоровьем. На самом деле, причина может быть иной.
Одной из причин раннего климакса могут быть преждевременные роды. Беременность и рождение ребенка — это значительный стресс для организма женщины, сопровождающийся серьезной гормональной перестройкой. Молодой организм может оказаться не готовым к таким изменениям, что приводит к сбоям в работе репродуктивной системы.
Ранний климакс — это не единственная проблема, связанная с родами в молодом возрасте. Существуют и другие риски:
- высокая вероятность повторной беременности в течение года;
- вторые роды могут быть значительно сложнее первых;
- риск рождения недоношенного ребенка или малыша с низким весом.
Вторые роды после первых, произошедших в юном возрасте, могут негативно сказаться на здоровье женщины. Организм не успевает восстановиться за короткий промежуток времени, и функция яичников может начать угасать уже после 30 лет.
Особенностью ранней менопаузы является то, что функция яичников может сохраняться в течение длительного времени. У женщины могут продолжаться овуляции и менструации, и около 25% из них способны забеременеть. В обычный постклимактерический период забеременеть уже не представляется возможным.
О приближении климакса можно судить по изменениям в менструальном цикле. Менструации становятся все реже: сначала задержка составляет неделю, затем месяц, а со временем они могут полностью исчезнуть или появляться раз в год.
Среди симптомов, указывающих на начало менопаузы, можно выделить:
- резкие колебания температуры, известные как «приливы»;
- увеличение потоотделения, особенно в ночное время.
У молодой женщины после родов может возникнуть временная менопауза, вызванная неправильным образом жизни, гормональными сбоями или хроническими заболеваниями половой системы. В таком случае говорить о настоящем климаксе не приходится.
По статистике, три из четырех женщин, столкнувшихся с менопаузой в раннем возрасте, испытывают «приливы».
Ранняя менопауза может проявляться и другими симптомами:
- сухость влагалища;
- резкие изменения настроения, раздражительность и депрессия;
- проблемы со сном;
- отсутствие менструаций.
Безусловно, все перечисленные симптомы могут быть следствием ранних родов, поэтому для точного диагноза необходима консультация специалиста.
Эксперты в области гинекологии отмечают, что симптомы климакса могут значительно варьироваться в зависимости от возраста, в котором женщина родила своих детей. Ранние роды, как правило, способствуют более плавному гормональному переходу, что может смягчить проявления климакса. Женщины, родившие в молодом возрасте, часто сообщают о менее выраженных симптомах, таких как приливы и перепады настроения. В то же время поздние роды могут привести к более резким изменениям в организме, что иногда вызывает более интенсивные симптомы. Исследования показывают, что у таких женщин может наблюдаться более выраженная усталость и эмоциональная нестабильность. Однако важно учитывать индивидуальные особенности каждой женщины, так как генетика, образ жизни и общее состояние здоровья также играют значительную роль в проявлении климакса.

Климакс после поздних родов
После поздних родов менопауза переносится легче, женщина чувствует себя здоровее. Климактерический период у женщины, которая родила после 35 лет, наступает позже. Симптомы его прихода такие:
- постепенное прекращение месячных;
- менее выраженные «приливы»;
- покраснение кожи при чрезмерной потливости;
- головная боль, повышение артериального давления;
- снижение сексуального влечения;
- смена настроения от апатии до агрессии;
- сухость во влагалище, проблемы с мочеиспусканием.
Есть и более серьезные признаки, а именно проблемы с суставами, хрупкость сосудов, заболевания сердца. На фоне менопаузы часто развиваются хронические болезни органов эндокринной и репродуктивной системы.
Очень важно при планировании беременности в возрасте после 40 лет обследоваться у гинеколога, ведь организм уже может подготавливаться к предстоящему климаксу и ему тяжело перенести беременность. В таком случае ребенок может родиться слабым.
После поздних родов часто проявляются хронические заболевания репродуктивной системы.
Сразу после поздних родов климакс редко наступает. Это случается у 10% женщин, родивших в возрасте 35 лет и старше.
| Симптом | Ранние роды (<35 лет) | Поздние роды (≥35 лет) |
|---|---|---|
| Приливы | Чаще интенсивные и продолжительные, более выражены | Могут быть менее интенсивными, но более продолжительными по времени |
| Нарушения сна | Более выражены, могут быть связаны с гормональными колебаниями и тревогой | Могут быть связаны с другими сопутствующими заболеваниями, например, бессонницей |
| Изменения настроения | Более резкие перепады настроения, раздражительность | Более выраженная депрессия или тревога |
| Сухость влагалища | Может проявляться раньше и быть более выраженной | Может быть менее выражена, но все равно присутствовать |
| Снижение либидо | Может быть значительным | Может быть менее выраженным, но все равно присутствовать |
| Ухудшение памяти и концентрации внимания | Может быть более выражено | Может быть связано с другими факторами, например, стрессом |
| Головные боли | Более частые и интенсивные | Могут быть связаны с другими сопутствующими заболеваниями |
| Увеличение веса | Может быть более выражено из-за гормональных изменений | Может быть связано с образом жизни и другими факторами |
| Боли в суставах и мышцах | Более распространены | Более распространены, могут быть связаны с возрастом |
Интересные факты
Вот несколько интересных фактов о симптомах климакса в зависимости от возраста, в котором женщина родила:
-
Влияние возраста на начало климакса: Исследования показывают, что женщины, которые рожают в более позднем возрасте, могут испытывать симптомы климакса позже, чем те, кто стал матерью в молодом возрасте. Это связано с тем, что гормональные изменения, происходящие во время беременности и лактации, могут влиять на уровень эстрогена и общее состояние репродуктивной системы.
-
Разнообразие симптомов: Симптомы климакса, такие как приливы, ночные поты и изменения настроения, могут проявляться по-разному у женщин, родивших в разные периоды жизни. У женщин, которые родили в молодом возрасте, симптомы могут быть более выраженными, в то время как у тех, кто стал матерью позже, они могут быть менее интенсивными.
-
Психологические аспекты: Женщины, родившие в более позднем возрасте, могут испытывать меньше стресса и тревоги в период климакса, что связано с более зрелым подходом к жизни и лучшей эмоциональной устойчивостью. Это может помочь смягчить симптомы и улучшить общее самочувствие в переходный период.

Диагностика климакса
Определение начала климактерического периода после родов представляет собой сложную задачу, поскольку он совпадает с послеродовым этапом. В этот период гормональный фон женщины еще не стабилизировался, что затрудняет различение между климаксом и процессом послеродовой реабилитации. В течение первого года после рождения ребенка у женщин могут наблюдаться симптомы, схожие с проявлениями климакса, такие как:
- отсутствие менструаций;
- сухость во влагалище;
- колебания настроения;
- общая слабость;
- снижение сексуального влечения;
- увеличение веса.
Даже после завершения грудного вскармливания менструальный цикл может не восстановиться в течение года. У женщин, родивших после 40 лет, процесс послеродовой реабилитации может занять еще больше времени. Поэтому врачи не спешат с диагнозом. Если менструации не возобновляются спустя год после окончания кормления, а симптомы климакса продолжают проявляться, можно говорить о наступлении менопаузы.
Диагностика основывается на жалобах пациентки. Обязательно проводится ультразвуковое исследование, а также анализ на уровень гормонов в крови. Наиболее точные данные для определения менопаузы получают по показателям фолликулостимулирующего гормона (ФСГ) и эстрадиола.
При раннем климаксе наблюдаются следующие признаки:
- вторичная аменорея;
- высокий уровень ФСГ и лютеинизирующего гормона (ЛГ);
- низкий уровень эстрадиола.
Для выяснения причин менопаузы, помимо консультации гинеколога, может потребоваться помощь онколога или эндокринолога. Прекращение работы репродуктивной системы после родов может быть вызвано наследственными факторами, истощением яичников, опухолями репродуктивных органов и молочных желез.
Рекомендуется посещать гинеколога раз в 6 или 12 месяцев.
Что делать, если после родов появились признаки климакса?
Остановить начавшийся процесс невозможно. Можно только оттянуть его на несколько лет в случае с ранним его наступлением. А вот ускорить менопаузу в возрасте после 55 лет намного проще.
Искусственно вызывают климакс у 5% старородящих женщин.
Для облегчения симптомов ранней менопаузы и ее отсрочки применяют такие методы:
- Гормонотерапия. Подойдет спираль, гормональные таблетки, эстрогеновые свечи и гели. К эстрогеносодержащим препаратам можно отнести «Премарин», «Эстриол» и «Дерместрил». Среди комбинированных средств выделяют «Анжелик», «Фемостон» и «Климен».
- Витаминно-минеральные комплексы. Хорошо пить препараты, содержащие витамин Е и фолиевую кислоту.
- Растительные средства. Эти препараты восполняют дефицит эстрогена. К ним относятся «Эстровэл», « Климадинон», «Ременс» и «Ци-Клим».
Обязательно нужно вести здоровый образ жизни и правильно питаться.
Чем раньше выявить причину наступления климактерического периода, тем эффективнее лечение.
Рождение ребенка возможно в любом возрасте, но организм может отреагировать на беременность и роды неожиданно. Только квалифицированная помощь специалистов и своевременное обращение в больницу помогут вновь обрести женское здоровье.

Влияние образа жизни на симптомы климакса
Образ жизни играет значительную роль в проявлении симптомов климакса, и его влияние может варьироваться в зависимости от того, когда женщина родила своих детей. Ранние и поздние роды могут оказывать различное воздействие на гормональный фон и общее состояние здоровья, что, в свою очередь, сказывается на симптомах менопаузы.
Женщины, которые родили в молодом возрасте, часто имеют более высокие уровни эстрогена и прогестерона в организме, что может способствовать более плавному переходу в климакс. Однако, если образ жизни такой женщины включает в себя стресс, неправильное питание или недостаток физической активности, это может усугубить симптомы климакса, такие как приливы, ночные поты и изменения настроения. Например, стресс может привести к повышенному уровню кортизола, который, в свою очередь, может нарушить баланс других гормонов.
С другой стороны, женщины, которые родили в более позднем возрасте, могут столкнуться с более выраженными симптомами климакса. Это связано с тем, что уровень эстрогена у них может быть ниже изначально, и переход в менопаузу может быть более резким. Однако, если такая женщина ведет активный образ жизни, занимается спортом и придерживается сбалансированной диеты, это может помочь смягчить симптомы. Физическая активность способствует улучшению кровообращения и снижению стресса, что может уменьшить частоту и интенсивность приливов.
Курение и употребление алкоголя также оказывают негативное влияние на симптомы климакса. Исследования показывают, что женщины, которые курят, чаще испытывают более тяжелые симптомы, такие как приливы и ночные поты. Алкоголь может усугублять проблемы со сном, что также является распространенным симптомом климакса. Поэтому отказ от вредных привычек может значительно улучшить качество жизни в период менопаузы.
Психоэмоциональное состояние женщины также имеет большое значение. Женщины, которые имеют поддержку семьи и друзей, а также активно занимаются хобби и интересами, могут легче переносить симптомы климакса. Психологический комфорт и отсутствие стресса способствуют гармонии в организме и могут смягчить проявления менопаузы.
Таким образом, образ жизни, включая физическую активность, питание, уровень стресса и психоэмоциональное состояние, существенно влияет на симптомы климакса. Женщины, независимо от возраста, в котором они стали матерями, могут улучшить свое самочувствие в период менопаузы, принимая осознанные решения о своем образе жизни.
Вопрос-ответ
Какие основные симптомы климакса могут проявляться после ранних родов?
Симптомы климакса после ранних родов могут включать приливы, ночное потоотделение, изменения настроения, нарушения сна и вагинальную сухость. Эти проявления могут варьироваться по интенсивности и продолжительности у разных женщин.
Как поздние роды влияют на начало климакса?
Поздние роды могут отсрочить начало климакса, так как гормональные изменения, связанные с беременностью и родами, могут продлить репродуктивный период. Однако каждая женщина индивидуальна, и факторы, такие как генетика и общее состояние здоровья, также играют важную роль.
Можно ли облегчить симптомы климакса после родов?
Да, симптомы климакса можно облегчить с помощью различных методов, включая изменение образа жизни, такие как регулярные физические упражнения, сбалансированное питание и управление стрессом. В некоторых случаях может быть рекомендована гормональная терапия или другие медикаментозные средства, но это следует обсудить с врачом.
Советы
СОВЕТ №1
Обратите внимание на изменения в своем организме. Важно отслеживать симптомы климакса, такие как приливы, изменения настроения и нарушения сна. Ведение дневника поможет вам лучше понять свои ощущения и вовремя обратиться к врачу.
СОВЕТ №2
Поддерживайте здоровый образ жизни. Регулярные физические упражнения, сбалансированное питание и отказ от вредных привычек могут значительно облегчить симптомы климакса и улучшить общее самочувствие.
СОВЕТ №3
Не стесняйтесь обращаться за поддержкой. Общение с близкими или участие в группах поддержки может помочь вам справиться с эмоциональными изменениями, связанными с климаксом. Психологическая поддержка играет важную роль в этот период.
СОВЕТ №4
Консультируйтесь с врачом о возможных вариантах лечения. Существуют различные методы, включая гормональную терапию и альтернативные средства, которые могут помочь облегчить симптомы климакса. Важно найти подходящий для вас вариант с учетом индивидуальных особенностей.